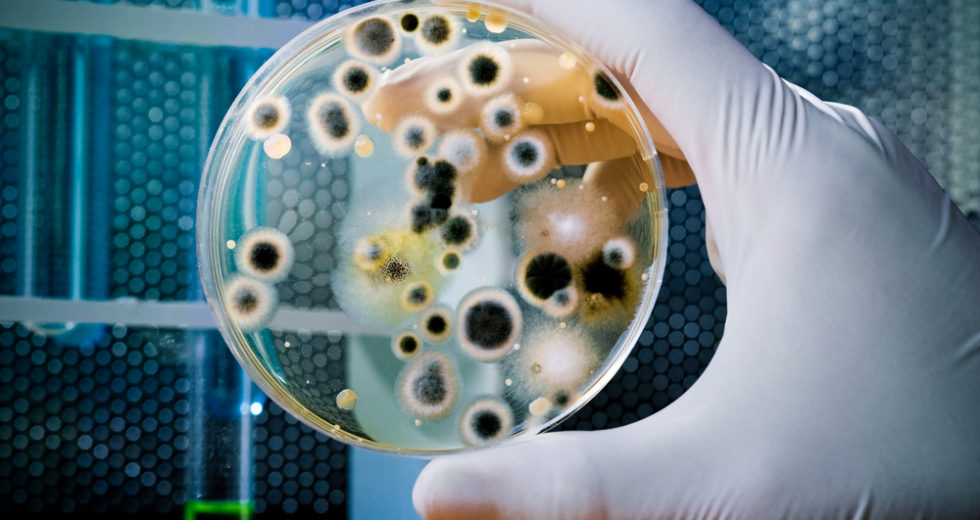
Disease Outbreaks Related To Swimming Pools And Hot Tubs Are Caused By Parasites And Bacteria

A new study elaborated by researchers from the University of California claims that exposure to the oceanic water can affect…

New research found that the bioactive cranberry extract composition makes the human become more receptive to smaller quantities of antibiotics.…

The new research was issued in the journal Nature Communications and conducted by UCL scientists takes us on a journey…

According to what a new study has found, fungi and bacteria are all over the International Space Station, and they…

Researchers from the University of Bayreuth discovered a new cloning method that can be used in many areas of biology,…

In the last decades, an affliction wiped off entire populations of frogs from all over the world. Researchers were surprised…

It’s normal to not like dust, which consists of dead skin, hair, bugs, soil, animal fur, and so on, as it…

A new study, in which the University of Birmingham participated, revealed that human gut bacteria present more than 6,000 antibiotic-resistant genes…

Are you frequently using your mobile phone while you’re on the toilet? If so, you will not do that anymore…

A recent study carried out by the University of Hong Kong revealed that each subway line in the city has…

A new joint study elaborated by the University of British Columbia, Caltech, and Lawrence Berkley National Laboratory has proven that…

An international team of scientists studied how bacteria behaved in salty chemical compounds and observed that bacteria could survive in…
Hotels are to blame for about 30% of all disease outbreaks in the United States associated with chlorinated or purified…

The plastic poured into the sea releases organic compounds that stimulate the growth of marine bacteria, according to a recent…

Researchers have already established that Mars had liquid water rivers and lakes on its surface during its early stages of…